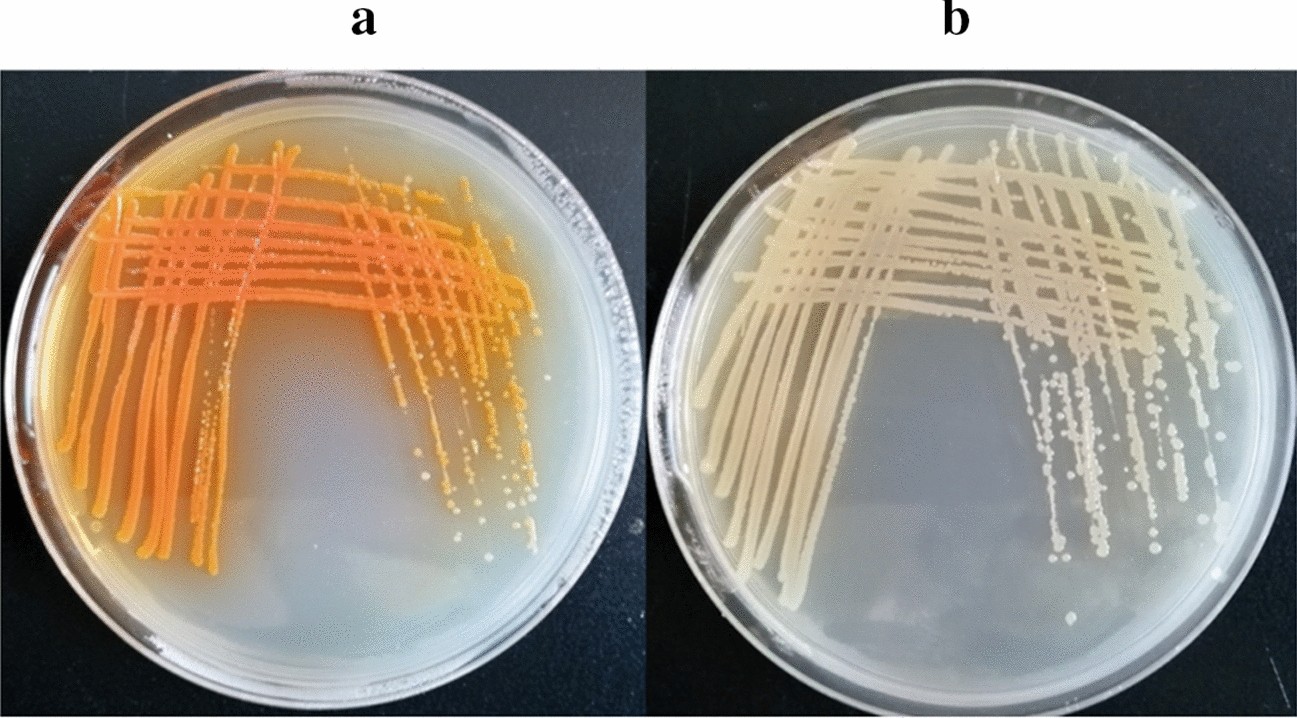
Figure 2

Figure 2

Colony morphology of P. chlororaphis Lzh-T5 and LDA-1. (a) Colony morphology of P. chlororaphis Lzh-T5. (b) Colony morphology of P. chlororaphis LDA-1.
Colony morphology of P. chlororaphis Lzh-T5 and LDA-1. (a) Colony morphology of P. chlororaphis Lzh-T5. (b) Colony morphology of P. chlororaphis LDA-1.